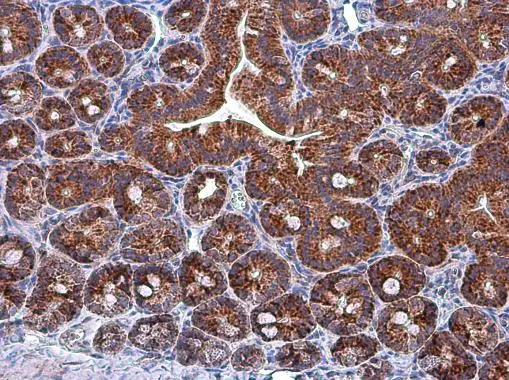
Grp75 antibody detects Grp75 protein at mitochondria in mouse duodenum by immunohistochemical analysis. Sample: Paraffin-embedded mouse duodenum. Grp75 antibody (GTX104407) diluted at 1:500. 
 Antigen Retrieval: Citrate buffer, pH 6.0, 15 min

HepG2 and mitochondria extracts (30 μg) were separated by SDS-PAGE, and the membrane was blotted with Grp75 antibody (GTX104407) diluted at 1:3000. The HRP-conjugated anti-rabbit IgG antibody (GTX213110-01) was used to detect the primary antibody.
Grp75 antibody
GTX104407
ApplicationsImmunoFluorescence, ImmunoPrecipitation, Western Blot, ImmunoCytoChemistry, ImmunoHistoChemistry, ImmunoHistoChemistry Paraffin
Product group Antibodies
ReactivityHuman, Mouse, Porcine, Rat
TargetHSPA9
Overview
- SupplierGeneTex
- Product NameGrp75 antibody
- Delivery Days Customer9
- Application Supplier NoteWB: 1:500-1:3000. ICC/IF: 1:100-1:1000. IHC-P: 1:100-1:1000. IP: 1:100-1:500. *Optimal dilutions/concentrations should be determined by the researcher.Not tested in other applications.
- ApplicationsImmunoFluorescence, ImmunoPrecipitation, Western Blot, ImmunoCytoChemistry, ImmunoHistoChemistry, ImmunoHistoChemistry Paraffin
- CertificationResearch Use Only
- ClonalityPolyclonal
- Concentration0.42 mg/ml
- ConjugateUnconjugated
- Gene ID3313
- Target nameHSPA9
- Target descriptionheat shock protein family A (Hsp70) member 9
- Target synonymsCRP40, CSA, EVPLS, GRP-75, GRP75, HEL-S-124m, HSPA9B, MOT, MOT2, MTHSP75, PBP74, SAAN, SIDBA4, stress-70 protein, mitochondrial, 75 kDa glucose-regulated protein, catecholamine-regulated protein 40, epididymis secretory sperm binding protein Li 124m, heat shock 70kD protein 9B, heat shock 70kDa protein 9 (mortalin), heat shock protein family A member 9, mortalin, perinuclear, mortalin-2, mortalin2, p66-mortalin, peptide-binding protein 74
- HostRabbit
- IsotypeIgG
- Protein IDP38646
- Protein NameStress-70 protein, mitochondrial
- Scientific DescriptionThis gene encodes a member of the heat shock protein 70 gene family. The encoded protein is primarily localized to the mitochondria but is also found in the endoplasmic reticulum, plasma membrane and cytoplasmic vesicles. This protein is a heat-shock cognate protein. This protein plays a role in cell proliferation, stress response and maintenance of the mitochondria. A pseudogene of this gene is found on chromosome 2.[provided by RefSeq, May 2010]
- ReactivityHuman, Mouse, Porcine, Rat
- Storage Instruction-20°C or -80°C,2°C to 8°C
- UNSPSC41116161